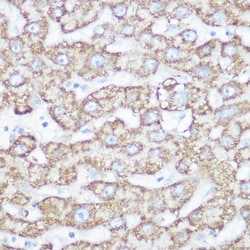
Invitrogen NDUFB7 Polyclonal Antibody 100 &mu;L; Unconjugated:Antibodies,

Learn More
Invitrogen™ NDUFB7 Polyclonal Antibody


Rabbit Polyclonal Antibody
Brand: Invitrogen™ PA589363
Description
Immunogen sequence: MGAHLVRRYL GDASVEPDPL QMPTFPPDYG FPERKEREMV ATQQEMMDAQ LRLQLRDYCA HHLIRLLKCK RDSFPNFLAC KQERHDWDYC EHRDYVMRMK EFERERRLLQ RKKRREKKAA ELAKGQGPGE VDPKVAL; Positive Samples: A-431, HL-60, MCF-7, Mouse brain, Mouse heart; Cellular Location: Mitochondrion inner membrane, Mitochondrion intermembrane space, Peripheral membrane protein.
The protein encoded by this gene is a subunit of the multisubunit NADH:ubiquinone oxidoreductase. Mammalian complex I is composed of 45 different subunits. It is located at the mitochondrial inner membrane. This protein has NADH dehydrogenase activity and oxidoreductase activity. It transfers electrons from NADH to the respiratory chain. The immediate electron acceptor for the enzyme is believed to be ubiquinone.
Specifications
| NDUFB7 | |
| Polyclonal | |
| Unconjugated | |
| Ndufb7 | |
| 1110002H15Rik; B18; cell adhesion protein SQM1; CI-B18; complex I B18 subunit; complex I-B18; NADH dehydrogenase (ubiquinone) 1 beta subcomplex, 7; NADH dehydrogenase (ubiquinone) 1 beta subcomplex, 7, 18kDa; NADH dehydrogenase [ubiquinone] 1 beta subcomplex subunit 7; NADH:ubiquinone oxidoreductase subunit B7; NADH-ubiquinone oxidoreductase B18 subunit; NDUFB7 | |
| Rabbit | |
| Affinity Chromatography | |
| RUO | |
| 361385, 4713, 66916 | |
| -20°C, Avoid Freeze/Thaw Cycles | |
| Liquid |
| ELISA, Immunohistochemistry (Paraffin), Western Blot, Immunocytochemistry | |
| 0.45 mg/mL | |
| PBS with 50% glycerol and 0.01% thimerosal; pH 7.3 | |
| P17568, Q9CR61 | |
| Ndufb7 | |
| Recombinant fusion protein containing a sequence corresponding to amino acids 1-137 of human NDUFB7 (NP_0041372). | |
| 100 μL | |
| Primary | |
| Human, Mouse, Rat | |
| Antibody | |
| IgG |
Your input is important to us. Please complete this form to provide feedback related to the content on this product.